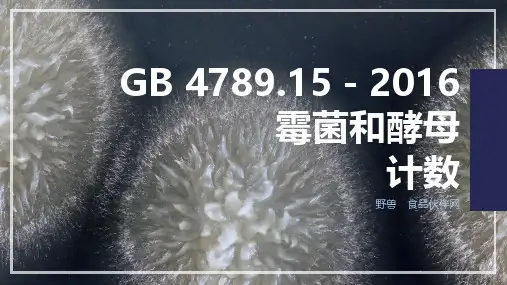

GBt4789系列标准to20110907国标委
- 格式:xlsx
- 大小:14.78 KB
- 文档页数:3

GB 4789.15-2016霉菌和酵母计数野兽食品伙伴网应用概况1标准修订2标准详解3质控要求4CONTENTSPART 1霉菌和酵母概况Overview of mould and yeastNational Food Safety Standard Food Microbiological Examination病毒原核生物原生生物真菌植物动物生物六界分类法真菌(菌物)已发现七万多种大型真菌是各类蕈类,小型真菌包括霉菌和酵母。
与动物、植物主要的区别是,真菌有细胞壁,主要成分为甲壳素(几丁质)。
相对于低等的细菌来说,霉菌和酵母生长缓慢,竞争力较弱,故只能在不利于细菌的环境中形成优势。
霉菌和酵母基本特性少数对人类有益,绝大多数不造成直接危害,但可导致食品的腐败变质,极少数能够致病或产生真菌毒素,危害极大。
细胞较大,代谢能力比细菌强100倍以上,故标准限量更严格。
危害生长水活度细菌0.90酵母0.87霉菌0.70卫生学意义霉菌和酵母计数主要用于判定样品被真菌污染程度,也可用于监测样品中真菌的性质和繁殖动态,进行样品的卫生学综合评价。
Mould and YeastPART 2检验方法标准修订Revision of Inspection Method Standard National Food Safety Standard Food Microbiological ExaminationGB 4789.15-84卫生部食品卫生监督检验所归口并负责起草。
主要起草人:罗雪云GB/T 4789.15-2003起草单位:中国疾病预防控制中心营养与食品安全所。
主要起草人:罗雪云、李风琴、李玉伟GB 4789.15-94卫生部食品卫生监督检验所归口并负责起草。
主要起草人:罗雪云GB 4789.15-2010未公布检验方法标准制修订GB 4789.15-2016起草单位:国家食品安全风险评估中心。
主要起草人:李凤琴、韩小敏、江涛、赵熙等参考国内外标准情况GB 4789.15-2010主要的技术性变化,就是培养温度从25℃~27℃修改为28℃。

食品检验标准精选(最新)G4789.1《GB4789.1~31、33~35-2003食品卫生微生物学检验》G4789.1《GB/T4789.1-2008食品卫生微生物学检验总则》G4789.2《GB/T4789.2-2008食品卫生微生物学检验菌落总数测定》G4789.3《GB/T4789.3-2008食品卫生微生物学检验大肠菌群计数》G4789.4《GB/T4789.4-2008食品卫生微生物学检验沙门氏菌检验》G4789.7《GB/T4789.7-2008食品卫生微生物学检验副溶血性弧菌检验》G4789.8《GB/T4789.8-2008食品卫生微生物学检验小肠结肠炎耶尔森氏菌检验》G4789.9《GB/T4789.9-2008食品卫生微生物学检验空肠弯曲菌检验》G4789.10《GB/T4789.10-2008食品卫生微生物学检验金黄色葡萄球菌检验》G4789.30《GB/T4789.30-2008食品卫生微生物学检验单核细胞增生李斯特氏菌检验》G4789.32《GB4789.32-2002食品卫生微生物学检验大肠菌群的快速检测》G4789.34《GB/T4789.34-2008食品卫生微生物学检验双歧杆菌检验》G4789.35《GB/T4789.35-2008食品卫生微生物学检验食品中乳酸菌检验》G4789.36《GB/T4789.36-2008食品卫生微生物学检验大肠埃希氏菌O157:H7/NM检验》G4789.37《GB/T4789.37-2008食品卫生微生物学检验金黄色葡萄球菌计数》G4789.38《GB/T4789.38-2008食品卫生微生物学检验大肠杆菌计数》G4789.39《GB/T4789.39-2008食品卫生微生物学检验粪大肠菌群计数》G4789.40《GB/T4789.40-2008食品卫生微生物学检验阪崎肠杆菌检验》G5009.7《GB/T5009.7-2008食品中还原糖的测定》G5009.8《GB/T5009.8-2008食品中蔗糖的测定》G5009.9《GB/T5009.9-2008食品中淀粉的测定》G5009.19《GB/T5009.19-2008食品中有机氯农药多组分残留量的测定》G5009.23《GB/T5009.23-2003食品中黄曲霉毒素Bl、B2、Gl、G2的测定》G5009.33《GB/T5009.33-2008食品中亚硝酸盐与硝酸盐的测定》G5009.49《GB/T5009.49-2008发酵酒及其配制酒卫生标准的分析方法》G5009.69《GB/T5009.69-2008食品罐头内壁环氧酚醛涂料卫生标准的分析方法》G5009.88《GB/T5009.88-2008食品中膳食纤维的测定》G5009.118《GB/T5009.118-2008谷物中T-2毒素的测定》G5009.146《GB/T5009.146-2008植物性食品中有机氯和拟除虫菊酯类农药多种残留量的测定》G5009.162《GB/T5009.162-2008动物性食品中有机氯农药和拟除虫菊酯农药多组分残留量的测定》G5009.190《GB/T5009.190-2006食品中指示性多氯联苯的测定》G5009.191《GB/T5009.191-2006食品中氯丙醇含量的测定》G5009.204《GB/T5009.204-2005食品中丙烯酰胺含量的测定方法气相色谱-质谱(GC-MS)法》G5009.205《GB/T5009.205-2007食品中二噁英及其类似物毒性当量的测定》G5009.206《GB/T5009.206-2007鲜河豚鱼中河豚毒素的测定》G5009.207《GB/T5009.207-2008糙米中50种有机磷农药残留量的测定》G5009.208《GB/T5009.208-2008食品中生物胺含量的测定》G5009.209《GB/T5009.209-2008谷物中玉米赤霉烯酮的测定》G5009.210《GB/T5009.210-2008食品中泛酸的测定》G5009.211《GB/T5009.211-2008食品中叶酸的测定》G5009.212《GB/T5009.212-2008贝类中腹泻性贝类毒素的测定》G5009.213《GB/T5009.213-2008贝类中麻痹性贝类毒素的测定》G5009.218《GB/T5009.218-2008水果和蔬菜中多种农药残留量的测定》G5009.219《GB/T5009.219-2008粮谷中矮壮素残留量的测定》G5009.220《GB/T5009.220-2008粮谷中敌菌灵残留量的测定》G5009.221《GB/T5009.221-2008粮谷中敌草快残留量的测定》G5009.222《GB/T5009.222-2008红曲类产品中桔青霉素的测定》G5127《GB5127-1998食品中敌敌畏﹑乐果等最大残留限量标准》G5530《GB/T5530-2005动植物油脂酸值和酸度测定》G5413《GB/T5413.1~32-1998婴幼儿配方食品和乳粉通用检验方法》G5535.1《GB/T5535.1-1998动植物油脂不皂化物测定:乙醚提取法》G5535.2《GB/T5535.2-1998动植物油脂不皂化物测定:己烷提取法》G5538《GB/T5538-2005动植物油脂过氧化值测定》G7628《GB/T7628-2008谷物中维生素B1测定》G7629《GB/T7629-2008谷物中维生素B2测定》G7718《GB7718-2004预包装食品标签通则》G9676《GB9676-2003牛乳及其制品中黄曲霉毒素M1限量》G9695.5《GB/T9695.5-2008肉与肉制品pH测定》G9695.6《GB/T9695.6-2008肉制品胭脂红着色剂测定》G9695.7《GB/T9695.7-2008肉与肉制品总脂肪含量测定》G9695.8《GB/T9695.8-2008肉与肉制品氯化物含量测定》G9695.10《GB/T9695.10-2008肉与肉制品六六六、滴滴涕残留量测定》G9695.18《GB/T9695.18-2008肉与肉制品总灰分测定》G9695.20《GB/T9695.20-2008肉与肉制品锌的测定》G9695.21《GB/T9695.21-2008肉与肉制品镁含量测定》G9695.25《GB/T9695.25-2008肉与肉制品维生素PP含量测定》G9695.29《GB/T9695.29-2008肉制品维生素C含量测定》G9696《GB/T9696-2008动植物油脂水分和挥发物含量测定》G10221《GB/T10221-1998感官分析术语》G10765《GB10765~10770-1998婴幼儿食品》G10784《GB/T10784-2006罐头食品分类》G10786《GB/T10786-2006罐头食品的检验方法》G12087《GB/T12087-2008淀粉水分测定烘箱法》G12399《GB/T12399-1996食品中硒的测定》G12456《GB/T12456-2008食品中总酸的测定》G12457《GB/T12457-2008食品中氯化钠的测定》G13025.7《GB/T13025.7-1999制盐工业通用试验方法:碘离子的测定》G13432《GB13432-2004预包装特殊膳食用食品标签通则》G14553《GB14553-2003粮食、水果和蔬菜中有机磷农药测定的气相色谱法》G14614.4《GB/T14614.4-2005小麦粉面团流变特性测定吹泡仪法》G14772《GB/T14772-2008食品中粗脂肪的测定》G15193《GB15193.1~21-2003食品安全性毒理学评价程序和方法》G16285《GB/T16285-2008食品中葡萄糖的测定酶-比色法和酶-电极法》G16286《GB/T16286-1996食品中蔗糖的测定方法》G16287《GB/T16287-1996食品中淀粉的测定方法》G16290《GB/T16290-1996感官分析方法学:使用标度评价食品》G16291《GB/T16291-1996感官分析:专家的选拔﹑培训和管理导则》G16319《GB16319-1996食品中敌百虫最大残留限量标准》G16320《GB16320-1996食品中亚胺硫磷最大残留限量标准》G16323《GB16323-1996食品中阿特拉津最大残留限量标准》G16333《GB16333-1996双甲脒等农药在食品中的最大残留限量》G16334《GB16334-1996γ辐照装置食品加工实用剂量学导则》G16336《GB16336-1996食品中阿特拉津残留量的测定》G16337《GB16337-1996大豆及谷物中氟磺胺草醚残留量的测定》G16338《GB/T16338-1996粮食中绿麦隆残留量的测定》G16339《GB/T16339-1996大米中禾大壮残留量的测定》G16340《GB/T16340-1996食品中灭幼脲残留量的测定》G16341《GB/T16341-1996食品中五氯硝基苯残留量的测定》G16342《GB/T16342-1996食品中锑的测定》G16343《GB/T16343-1996食品中镍的测定》G16346《GB/T16346-1996食品中诱惑红的测定》G16740《GB16740-1998保健食品通用标准》G16860《GB/T16860-1998感官分析方法:质地剖面检验》G16861《GB/T16861-1998感官分析:通过多元分析方法鉴定和选择用于建立感官剖面的描述词》G16919《GB/T16919-1998食用螺旋藻粉》G17022《GB17022-1998盐碘现场半定量检测包质量评定标准》G17321《GB/T17321-1998感官分析方法:二、三点检验》G17328《GB17328-1998食品中稳杀得、精稳杀得残留量的测定》G17329《GB17329-1998食品中双甲脒残留量的测定》G17330《GB17330-1998食品中甲基异柳磷残留量的测定》G17331《GB17331-1998食品中有机磷和氨基甲酸酯类农药多种残留的测定》G17332《GB17332-1998食品中有机氯和拟除虫菊酯类农药多种残留的测定》G17333《GB17333-1998食品中除虫脲残留量的测定》G17334《GB17334-1998食品中游离棉酚的测定》G17335《GB17335-1998食品中栀子黄的测定》G17336《GB17336-1998食品中红曲色素的测定》G17337《GB17337-1998食品中锗的测定》G17338《GB17338-1998食品包装用丙烯腈-苯乙烯成型品中残留丙烯腈单体的测定》G17356《GB/T17356.1~5-1998西洋参加工产品分等质量标准》G17375《GB/T17375-1998动植物油脂灰分测定法》G17406《GB/T17406-1998食品中植酸的测定》G17407《GB/T17407-1998食品中微生素B6的测定》G17408《GB/T17408-1998大米中稻瘟灵残留量的测定》G17527《GB/T17527-1998胡椒精油含量测定方法》G17528《GB/T17528-1998胡椒碱含量的测定:分光光度法》G18407.5《GB/T18407.5-2003农产品安全质量:无公害乳与乳制品产地环境要求》G18627《GB/T18627-2002食品中八甲磷残留量的测定方法》G18628《GB/T18628-2002食品中乙滴涕残留量的测定方法》G18629《GB/T18629-2002食品中扑草净残留量的测定方法》G18630《GB/T18630-2002蔬菜中有机磷及氨基甲酸酯农药残留量的简易检验方法》G18782《GB/T18782-2002调味品中3-氯-1,2-丙二醇的测定》G18962《GB/T18962-2003制盐工业通用试验方法铅离子的测定》G18979《GB/T18979-2003食品中黄曲霉素的测定》G19338《GB19338-2003蔬菜中硝酸盐限量》G19339《GB/T19338-2003蔬菜中硝酸盐含量的快速测定》G19426《GB/T19426-2006蜂蜜、果汁和果酒中497种农药及相关化学品残留量的测定气相色谱-质谱法》G19648《GB/T19648-2006水果和蔬菜中500种农药及相关化学品残留量的测定气相色谱-质谱法》G19649《GB/T19649-2006粮谷中475种农药及相关化学品残留量的测定气相色谱-质谱法》G19650《GB/T19650-2005动物组织中437种农药多残留测定方法气相色谱-质谱和液相色谱-串联质谱法》G19495.1《GB/T19495.1-2004转基因产品检测通用要求和定义》G19495.2《GB/T19495.2-2004转基因产品检测实验室技术要求》G19495.3《GB/T19495.3-2004转基因产品检测核酸提取纯化方法》G19495.4《GB/T19495.4-2004转基因产品检测核酸定性PCR检测方法》G19495.5《GB/T19495.5-2004转基因产品检测核酸定量PCR检测方法》G19495.6《GB/T19495.6-2004转基因产品检测基因芯片检测方法》G19495.7《GB/T19495.7-2004转基因产品检测抽样和制样方法》G19495.8《GB/T19495.8-2004转基因产品检测蛋白质检测方法》G20188《GB/T20188-2006小麦粉中溴酸盐的测定离子色谱法》G20364《GB/T20364-2006动物源产品中聚醚类残留量的测定》G20361《GB/T20361-2006水产品中孔雀石绿和结晶紫残留量的测定高效液相色谱荧光检测法》G20362《GB/T20362-2006鸡蛋中氯羟吡啶残留量的检测方法高效液相色谱法》G20373《GB/T20373-2006变性淀粉中乙酰基含量的测定酶法》G20374《GB/T20374-2006变性淀粉氧化淀粉羧基含量的测定》G20375《GB/T20375-2006变性淀粉羧甲基淀粉中羧甲基含量的测定》G20376《GB/T20376-2006变性淀粉中羟丙基含量的测定质子核磁共振波谱法》G20377《GB/T20377-2006变性淀粉乙酰化二淀粉己二酸酯中己二酸含量的测定气相色谱法》G20378《GB/T20378-2006原淀粉淀粉含量的测定旋光法》G20379《GB/T20379-2006淀粉衍生物葡萄糖浆、果糖浆和氢化葡萄糖浆成分的测定高效液相色谱法》G20380.1《GB/T20380.1-2006淀粉及其制品重金属含量:原子吸收光谱法测定砷含量》G20380.2《GB/T20380.2-2006淀粉及其制品重金属含量:原子吸收光谱法测定汞含量》G20380.3《GB/T20380.3-2006淀粉及其制品重金属含量:电热原子吸收光谱法测定铅含量》G20380.4《GB/T20380.4-2006淀粉及其制品重金属含量:电热原子吸收光谱法测定镉含量》G20741《GB/T20741-2006畜禽肉中地塞米松残留量的测定栩色谱-串联质潜法》G20743《GB/T20743-2006猪肉、猪肝和猪肾中杆菌肽残留量的测定液相色-串联质谱法》G20744《GB/T20744-2006蜂蜜中甲硝唑、洛硝哒唑、二甲硝咪唑残留量的测定液相色谱-串联质谱法》G20745《GB/T20745-2006畜禽肉中癸氧唪酯残留景的测定液相色谱一荧光检测法》G20746《GB/T20746-2006牛、猪的肝脏和肌肉中卡巴氧和喹乙醇及代谢物残留量的测定色谱-质谱法》G20747《GB/T20747-2006牛和猪肌肉中安乃近代谢物残留量的测定液相色谱-串联质谱法》G20748《GB/T20748-2006牛肝和牛肉中阿维菌素类约物残留量的测定液相色谱一串联质谱法》G20750《GB/T20750-2006牛肌肉中氟胺烟酸残帘擘的测定液相色谱一紫外检测法》G20751《GB/T20751-2006鳗鱼及制品中十五种喹酮类物残留量的测定液相色谱-串联质谱法》G20752《GB/T20752-2006猪肉、牛肉、鸡肉和水产品中硝基呋喃类代谢物残留量的测定色谱-质谱法》G20753《GB/T20753-2006牛和猪脂肪中醋酸美仑孕酮、醋酸氯地孕酮和醋酸甲地孕酮残留量的测定》G20754《GB/T20754-2006畜禽肉中保泰松残留量的测定液相色谱一紫外检测法》G20755《GB/T20755-2006畜禽肉中九种青霉素类药物残留量的测定液相色谱一串联质谱法》G20756《GB/T20756-2006可食动物肌肉、肝脏和水产品中氯霉素、甲砜霉素和氟苯尼考残留量的测定》G20757《GB/T20757-2006蜂蜜中十四种喹诺酮类药物残留量的测定液相色谱-串联质谱法》G20758《GB/T20758-2006牛肝和牛肉中睾酮、表睾酮、孕酮残留量的测定液相色谱一串联质谱法》G20759《GB/T20759-2006畜禽肉中十六种磺胺类药物残帘量的测定液相色谱一串联质谱法》G20760《GB/T20760-2006牛肌肉、肝、肾中的α-群勃龙、β-群勃龙残留量的测定色谱-串联质谱法》G20762《GB/T20762-2006畜禽肉中林可霉素、竹桃霉素、红霉素、替米考星…残留量的测定》G20763《GB/T20763-2006猪肾和肌肉组织中乙酰丙嗪、氯丙嗪、氟哌啶醇、丙酰二甲氨..残留量的测定》G20764《GB/T20764-2006可食动物肌肉中土霉素、四环素、金霉素、强力霉素残留量的测定液相色谱法》G20765《GB/T20765-2006猪肝脏、肾脏、肌肉组织中维吉尼霉素Ml残留量的测定液相色谱-串联质谱法》G20766《GB/T20766-2006牛猪肝肾和肌肉组织中玉米赤霉醇、卡米赤霉酮、贱留量的测定色谱一质谱法》G20767《GB/T20767-2006牛尿中玉米赤霉醇、己烯酚、己烷雌酚、双烯雌酚贱留量的测定色谱-质谱法》G20768《GB/T20768-2006鱼和虾中有毒牛物胺的测定液相色谱-紫外检测法》G20769《GB/T20769-2006水果和蔬菜中405种农药及相关化学品残留量的测定液相色谱一串联质谱法》G20796《GB/T20796-2006肉与肉制品中甲萘威残留量的测定》G20797《GB/T20797-2006肉与肉制品中喹乙醇残留量的测定》G21164《GB/T21164-2007蜂王浆中链霉素、双氢链霉素残留量测定液相色谱法》G21165《GB/T21165-2007肠衣中氯霉素残留量的测定液相色谱-串联质谱法》G21166《GB/T21166-2007肠衣中硝基呋喃类代谢物残留量的测定液相色谱-串联质谱法》G21167《GB/T21167-2007蜂王浆中硝基呋喃类代谢物残留量的测定液相色谱-串联质谱法》G21168《GB/T21168-2007蜂蜜中泰乐菌素残留量的测定液相色谱-串联质谱法》G21169《GB/T21169-2007蜂蜜中双甲脒及其代谢物残留量测定-液相色谱法》G21172《GB/T21172-2007感官分析食品颜色评价的总则和检验方法》G21173《GB/T21173-2007动物源性食品中磺胺类药物残留测定方法放射受体分析法》G21174《GB/T21174-2007动物源性食品中β-内酰胺类药物残留测定方法放射受体分析法》G21234《GB/T21234-2007铁强化酱油中乙二胺四乙酸铁钠的测定》G21235《GB/Z21235-2007微生物危险性评估的原理和指南》G21265《GB/T21265-2007辣椒辣度的感官评价方法》G21266《GB/T21266-2007辣椒及辣椒制品中辣椒素类物质测定及辣度表示方法》G21310《GB/T21310-2007动物源性食品中甲状腺拮抗剂残留量检测方法高效液相色谱/串联质谱法》G21311《GB/T21311-2007动物源性食品中硝基呋喃类药物代谢物残留量检测方法高效液相色谱/串联质谱法》G21312《GB/T21312-2007动物源性食品中14种喹诺酮药物残留检测方法液相色谱-质谱/质谱法》G21313《GB/T21313-2007动物源性食品中β-受体激动剂残留检测方法液相色谱-质谱/质谱法》G21314《GB/T21314-2007动物源性食品中头孢匹林、头孢噻呋残留量检测方法液相色谱/质谱法》G21315《GB/T21315-2007动物源性食品中青霉素族抗生素残留量检测方法液相色谱-质谱/质谱法》G21316《GB/T21316-2007动物源性食品中磺胺类药物残留量的测定高效液相色谱-质谱/质谱法》G21317《GB/T21317-2007动物源性食品中四环素类兽药残留量检测方法液相色谱-质谱/质谱法与高效液相色谱法》G21318《GB/T21318-2007动物源性食品中硝基咪唑残留量检验方法》G21319《GB/T21319-2007动物源食品中阿维菌素类药物残留的测定酶联免疫吸附法》G21320《GB/T21320-2007动物源食品中阿维菌素类药物残留量的测定液相色谱-串联质谱法》G21321《GB/T21321-2007动物源食品中阿维菌素类药物残留量的测定免疫亲和-液相色谱法》G21322《GB/T21322-2007动物源食品中3-甲基喹喔啉-2-羧酸残留的测定高效液相色谱法》G21323《GB/T21323-2007动物组织中氨基糖苷类药物残留量的测定高效液相色谱-质谱/质谱法》G21324《GB/T21324-2007食用动物肌肉和肝脏中苯并咪唑类药物残留量检测方法》G21658《GB/T21658-2008进出境植物和植物产品有害生物风险分析工作指南》G21659《GB/T21659-2008植物检疫措施准则辐照处理》G21676《GB/T21676-2008乳与乳制品脂肪酸的测定气相色谱法》G21700《GB/Z21700-2008出口鳗鱼制品质量安全控制规范》G21701《GB/Z21701-2008出口禽肉及制品质量安全控制规范》G21702《GB/Z21702-2008出口水产品质量安全控制规范》3G21703《GB/T21703-2008乳与乳制品中苯甲酸和山梨酸的测定》G21704《GB/T21704-2008乳与乳制品中非蛋白氮含量的测定》G21722《GB/Z21722-2008出口茶叶质量安全控制规范》G21724《GB/Z21724-2008出口蔬菜质量安全控制规范》G21911《GB/T21911-2008食品中邻苯二甲酸酯的测定》G21912《GB/T21912-2008食品中二氧化钛的测定》G21913《GB/T21913-2008食品中滑石粉的测定》G21914《GB/T21914-2008茶饮料中乙酸苄酯的测定气相色谱法》G21915《GB/T21915-2008食品中纳他霉素的测定液相色谱法》G21916《GB/T21916-2008水果罐头中合成着色剂的测定高效液相色谱法》G21917《GB/T21917-2008饮料中乙基麦芽酚的测定方法》G21918《GB/T21918-2008食品中硼酸的测定》G21922《GB/Z21922-2008食品营养成分基本术语》G21927《GB/T21927-2008食品中叔丁基对苯二酚的测定高效液相色谱法》G21928《GB/T21928-2008食品塑料包装材料中邻苯二甲酸酯的测定》G21981《GB/T21981-2008动物源食品中激素多残留检测方法液相色谱-质谱/质谱法》28.80G21982《GB/T21982-2008动物源食品中玉米赤霉醇、β-玉米赤霉醇、α-玉米赤霉烯醇、β-玉米赤霉烯醇、玉米赤霉酮和玉米赤霉烯酮残留量检测方法液相色谱-质谱/质谱法》G22031《GB/T22031-2008干酪及加工干酪制品中添加的柠檬酸盐含量的测定酶-比色法》G22035《GB/T22035-2008乳及乳制品中植物油的检验气相色谱法》G22110《GB/T22110-2008食品中反式脂肪酸的测定气相色谱法》G22220《GB/T22220-2008食品中胆固醇的测定高效液相色谱法》G22221《GB/T22221-2008食品中果糖、葡萄糖、蔗糖、麦芽糖、乳糖的测定高效液相色谱法》G22222《GB/T22222-2008食品中木糖醇、山梨醇、麦芽糖醇的测定高效液相色谱法》G22223《GB/T22223-2008食品中总脂肪、饱和脂肪(酸)、不饱和脂肪(酸)的测定水解提取-气相色谱法》G22224《GB/T22224-2008食品中膳食纤维的测定酶重量法和酶重量法-液相色谱法》SB10386《SB/T10386-2004禽畜肉中氯霉素的测定》SB10387《SB/T10387-2004禽畜肉和水产品中呋喃唑酮的测定》SB10388《SB/T10388-2004畜禽肉中磺胺二甲嘧啶的测定》SB10389《SB/T10389-2004肉与肉制品中山梨酸的测定》Q2344《QB/T2344-1998两性表面活性脂肪烷基二甲甜菜碱》Q2345《QB/T2345-1998脂肪烷基二甲基甜素碱平均相对分子质量的测定》 WS234《WS/T234-2002食品中放射性物质检验镅-240的测定》NY447《NY/T447-2001韭菜中甲胺磷等7种农药残留检测方法》NY448《NY/T448-2001蔬菜上有机磷等农药残毒块速检测方法》NY449《NY/T449-2001玉米种子纯度盐溶蛋白电泳鉴定方法》NY672《NY/T672-2003转基因植物及其产品检测通用要求》NY673《NY/T673-2003转基因植物及其产品检测抽样》NY674《NY/T674-2003转基因植物及其产品检测DNA提取和纯化》NY675《NY/T675-2003转基因植物及其产品检测大豆定性PCR方法》NY5295《NY/T5295-2004无公害食品产地环境评价准则》HJ80《HJ/T80-2001有机食品技术规范》。


蜂蜜卫生标准1 主题内容与适用范围本标准规定了蜂蜜的卫生要求、检验方法。
本标准适用于以中华蜜蜂和西方蜜蜂及其杂交蜂种所采集酿造的天然加工蜂蜜。
2 引用标准GB 4789.2 食品卫生微生物学检验菌落总数测定GB 4789.3 食品卫生微生物学检验大肠菌群测定GB 4789.4 食品卫生微生物学检验沙门氏菌检验GB 4789.5 食品卫生微生物学检验志贺氏菌检验GB 4789.10 食品卫生微生物学检验葡萄球菌检验GB 4789.11 食品卫生微生物学检验溶血性链球菌检验GB 4789.15 食品卫生微生物学检验霉菌和酵母数测定GB 5009.12 食品中铅的测定方法GB 5009.14 食品中锌的测定方法3 卫生要求3.1 感官指标常温下呈透明或半透明粘稠状液体,较低温度下可出现结晶,具蜜源植物特有的色、香、味,无涩、麻、辛辣等异味,天然蜂蜜经加工后,无死蜂、幼虫及其他杂质。
3.2 理化指标理化指标见表1。
表13.3 微生物指标微生物指标见表2。
表24 检验方法铅的检验方法按GB 5009.12执行。
锌的检验方法按GB 5009.14执行。
细菌总数检验方法按GB 4789.2执行。
大肠菌群检验方法按GB 4789.3执行。
致病菌检验方法按GB 4789.4、GB 4789.5、GB 4789.10、GB 4789.11执行。
霉菌总数测定按GB 4789.15执行。
附加说明:本标准由卫生部卫生监督司提出。
本标准由广东省食品卫生监督检验所负责起草。
本标准主要起草人陈卫东、黄妙英、戴滢。
本标准由卫生部委托技术归口单位卫生部食品卫生监督检验所负责解释。



中华人民共和国国家标准G B4789.10 2016食品安全国家标准食品微生物学检验金黄色葡萄球菌检验2016-12-23发布2017-06-23实施中华人民共和国国家卫生和计划生育委员会前言本标准代替G B4789.10 2010‘食品安全国家标准食品微生物学检验金黄色葡萄球菌检验“㊁S N/T0172 2010‘进出口食品中金黄色葡萄球菌检验方法“㊁S N/T2154 2008‘进出口食品中凝固酶阳性葡萄球菌检测方法兔血浆纤维蛋白原琼脂培养基技术“㊂本标准与G B4789.10 2010相比,主要变化如下:试验用增菌液统一为7.5%氯化钠肉汤㊂食品安全国家标准食品微生物学检验金黄色葡萄球菌检验1范围本标准规定了食品中金黄色葡萄球菌(S t a p h y l o c o c c u s a u r e u s)的检验方法㊂本标准第一法适用于食品中金黄色葡萄球菌的定性检验;第二法适用于金黄色葡萄球菌含量较高的食品中金黄色葡萄球菌的计数;第三法适用于金黄色葡萄球菌含量较低的食品中金黄色葡萄球菌的计数㊂2设备和材料除微生物实验室常规灭菌及培养设备外,其他设备和材料如下:2.1恒温培养箱:36ħʃ1ħ㊂2.2冰箱:2ħ~5ħ㊂2.3恒温水浴箱:36ħ~56ħ㊂2.4天平:感量0.1g㊂2.5均质器㊂2.6振荡器㊂2.7无菌吸管:1m L(具0.01m L刻度)㊁10m L(具0.1m L刻度)或微量移液器及吸头㊂2.8无菌锥形瓶:容量100m L㊁500m L㊂2.9无菌培养皿:直径90mm㊂2.10涂布棒㊂2.11p H计或p H比色管或精密p H试纸㊂3培养基和试剂3.17.5%氯化钠肉汤:见A.1㊂3.2血琼脂平板:见A.2㊂3.3 B a i r d-P a r k e r琼脂平板:见A.3㊂3.4脑心浸出液肉汤(B H I):见A.4㊂3.5兔血浆:见A.5㊂3.6稀释液:磷酸盐缓冲液:见A.6㊂3.7营养琼脂小斜面:见A.7㊂3.8革兰氏染色液:见A.8㊂3.9无菌生理盐水:见A.9㊂第一法金黄色葡萄球菌定性检验4检验程序金黄色葡萄球菌定性检验程序见图1㊂图1金黄色葡萄球菌检验程序5操作步骤5.1样品的处理称取25g样品至盛有225m L7.5%氯化钠肉汤的无菌均质杯内,8000r/m i n~10000r/m i n均质1m i n~2m i n,或放入盛有225m L7.5%氯化钠肉汤无菌均质袋中,用拍击式均质器拍打1m i n~ 2m i n㊂若样品为液态,吸取25m L样品至盛有225m L7.5%氯化钠肉汤的无菌锥形瓶(瓶内可预置适当数量的无菌玻璃珠)中,振荡混匀㊂5.2增菌将上述样品匀液于36ħʃ1ħ培养18h~24h㊂金黄色葡萄球菌在7.5%氯化钠肉汤中呈混浊生长㊂5.3分离将增菌后的培养物,分别划线接种到B a i r d-P a r k e r平板和血平板,血平板36ħʃ1ħ培养18h~ 24h㊂B a i r d-P a r k e r平板36ħʃ1ħ培养24h~48h㊂5.4初步鉴定金黄色葡萄球菌在B a i r d-P a r k e r平板上呈圆形,表面光滑㊁凸起㊁湿润㊁菌落直径为2mm~3mm,颜色呈灰黑色至黑色,有光泽,常有浅色(非白色)的边缘,周围绕以不透明圈(沉淀),其外常有一清晰带㊂当用接种针触及菌落时具有黄油样黏稠感㊂有时可见到不分解脂肪的菌株,除没有不透明圈和清晰带外,其他外观基本相同㊂从长期贮存的冷冻或脱水食品中分离的菌落,其黑色常较典型菌落浅些,且外观可能较粗糙,质地较干燥㊂在血平板上,形成菌落较大,圆形㊁光滑凸起㊁湿润㊁金黄色(有时为白色),菌落周围可见完全透明溶血圈㊂挑取上述可疑菌落进行革兰氏染色镜检及血浆凝固酶试验㊂5.5确证鉴定5.5.1染色镜检:金黄色葡萄球菌为革兰氏阳性球菌,排列呈葡萄球状,无芽胞,无荚膜,直径约为0.5μm~1μm㊂5.5.2血浆凝固酶试验:挑取B a i r d-P a r k e r平板或血平板上至少5个可疑菌落(小于5个全选),分别接种到5m LB H I和营养琼脂小斜面,36ħʃ1ħ培养18h~24h㊂取新鲜配制兔血浆0.5m L,放入小试管中,再加入B H I培养物0.2m L~0.3m L,振荡摇匀,置36ħʃ1ħ温箱或水浴箱内,每半小时观察一次,观察6h,如呈现凝固(即将试管倾斜或倒置时,呈现凝块)或凝固体积大于原体积的一半,被判定为阳性结果㊂同时以血浆凝固酶试验阳性和阴性葡萄球菌菌株的肉汤培养物作为对照㊂也可用商品化的试剂,按说明书操作,进行血浆凝固酶试验㊂结果如可疑,挑取营养琼脂小斜面的菌落到5m LB H I,36ħʃ1ħ培养18h~48h,重复试验㊂5.6葡萄球菌肠毒素的检验(选做)可疑食物中毒样品或产生葡萄球菌肠毒素的金黄色葡萄球菌菌株的鉴定,应按附录B检测葡萄球菌肠毒素㊂6结果与报告6.1结果判定:符合5.4㊁5.5,可判定为金黄色葡萄球菌㊂6.2结果报告:在25g(m L)样品中检出或未检出金黄色葡萄球菌㊂第二法金黄色葡萄球菌平板计数法7检验程序金黄色葡萄球菌平板计数法检验程序见图2㊂图2金黄色葡萄球菌平板计数法检验程序8操作步骤8.1样品的稀释8.1.1固体和半固体样品:称取25g样品置于盛有225m L磷酸盐缓冲液或生理盐水的无菌均质杯内,8000r/m i n~10000r/m i n均质1m i n~2m i n,或置于盛有225m L稀释液的无菌均质袋中,用拍击式均质器拍打1m i n~2m i n,制成1ʒ10的样品匀液㊂8.1.2液体样品:以无菌吸管吸取25m L样品置于盛有225m L磷酸盐缓冲液或生理盐水的无菌锥形瓶(瓶内预置适当数量的无菌玻璃珠)中,充分混匀,制成1ʒ10的样品匀液㊂8.1.3用1m L无菌吸管或微量移液器吸取1ʒ10样品匀液1m L,沿管壁缓慢注于盛有9m L磷酸盐缓冲液或生理盐水的无菌试管中(注意吸管或吸头尖端不要触及稀释液面),振摇试管或换用1支1m L 无菌吸管反复吹打使其混合均匀,制成1ʒ100的样品匀液㊂8.1.4按8.1.3操作程序,制备10倍系列稀释样品匀液㊂每递增稀释一次,换用1次1m L无菌吸管或吸头㊂8.2样品的接种根据对样品污染状况的估计,选择2个~3个适宜稀释度的样品匀液(液体样品可包括原液),在进行10倍递增稀释的同时,每个稀释度分别吸取1m L样品匀液以0.3m L㊁0.3m L㊁0.4m L接种量分别加入三块B a i r d-P a r k e r平板,然后用无菌涂布棒涂布整个平板,注意不要触及平板边缘㊂使用前,如B a i r d-P a r k e r平板表面有水珠,可放在25ħ~50ħ的培养箱里干燥,直到平板表面的水珠消失㊂8.3培养在通常情况下,涂布后,将平板静置10m i n,如样液不易吸收,可将平板放在培养箱36ħʃ1ħ培养1h;等样品匀液吸收后翻转平板,倒置后于36ħʃ1ħ培养24h~48h㊂8.4典型菌落计数和确认8.4.1金黄色葡萄球菌在B a i r d-P a r k e r平板上呈圆形,表面光滑㊁凸起㊁湿润㊁菌落直径为2mm~ 3mm,颜色呈灰黑色至黑色,有光泽,常有浅色(非白色)的边缘,周围绕以不透明圈(沉淀),其外常有一清晰带㊂当用接种针触及菌落时具有黄油样黏稠感㊂有时可见到不分解脂肪的菌株,除没有不透明圈和清晰带外,其他外观基本相同㊂从长期贮存的冷冻或脱水食品中分离的菌落,其黑色常较典型菌落浅些,且外观可能较粗糙,质地较干燥㊂8.4.2选择有典型的金黄色葡萄球菌菌落的平板,且同一稀释度3个平板所有菌落数合计在20C F U~ 200C F U之间的平板,计数典型菌落数㊂8.4.3从典型菌落中至少选5个可疑菌落(小于5个全选)进行鉴定试验㊂分别做染色镜检,血浆凝固酶试验(见5.5);同时划线接种到血平板36ħʃ1ħ培养18h~24h后观察菌落形态,金黄色葡萄球菌菌落较大,圆形㊁光滑凸起㊁湿润㊁金黄色(有时为白色),菌落周围可见完全透明溶血圈㊂9结果计算9.1若只有一个稀释度平板的典型菌落数在20C F U~200C F U之间,计数该稀释度平板上的典型菌落,按式(1)计算㊂9.2 若最低稀释度平板的典型菌落数小于20C F U ,计数该稀释度平板上的典型菌落,按式(1)计算㊂9.3 若某一稀释度平板的典型菌落数大于200C F U ,但下一稀释度平板上没有典型菌落,计数该稀释度平板上的典型菌落,按式(1)计算㊂9.4 若某一稀释度平板的典型菌落数大于200C F U ,而下一稀释度平板上虽有典型菌落但不在20C F U~200C F U 范围内,应计数该稀释度平板上的典型菌落,按式(1)计算㊂9.5 若2个连续稀释度的平板典型菌落数均在20C F U~200C F U 之间,按式(2)计算㊂9.6 计算公式式(1):T =A BC d(1)式中:T样品中金黄色葡萄球菌菌落数;A某一稀释度典型菌落的总数;B某一稀释度鉴定为阳性的菌落数;C某一稀释度用于鉴定试验的菌落数;d 稀释因子㊂式(2):T =A 1B 1/C 1+A 2B 2/C 21.1d(2)式中:T样品中金黄色葡萄球菌菌落数;A 1第一稀释度(低稀释倍数)典型菌落的总数;B 1第一稀释度(低稀释倍数)鉴定为阳性的菌落数;C 1第一稀释度(低稀释倍数)用于鉴定试验的菌落数;A 2第二稀释度(高稀释倍数)典型菌落的总数;B 2第二稀释度(高稀释倍数)鉴定为阳性的菌落数;C 2第二稀释度(高稀释倍数)用于鉴定试验的菌落数;1.1计算系数;d 稀释因子(第一稀释度)㊂10 报告根据9中公式计算结果,报告每g (m L )样品中金黄色葡萄球菌数,以C F U /g(m L )表示;如T 值为0,则以小于1乘以最低稀释倍数报告㊂第三法 金黄色葡萄球菌M P N 计数11 检验程序金黄色葡萄球菌M P N 计数检验程序见图3㊂图3金黄色葡萄球菌M P N法检验程序12操作步骤12.1样品的稀释按8.1进行㊂12.2接种和培养12.2.1根据对样品污染状况的估计,选择3个适宜稀释度的样品匀液(液体样品可包括原液),在进行10倍递增稀释的同时,每个稀释度分别接种1m L样品匀液至7.5%氯化钠肉汤管(如接种量超过1m L,则用双料7.5%氯化钠肉汤),每个稀释度接种3管,将上述接种物36ħʃ1ħ培养,18h~24h㊂12.2.2用接种环从培养后的7.5%氯化钠肉汤管中分别取培养物1环,移种于B a i r d-P a r k e r平板36ħʃ1ħ培养,24h~48h㊂12.3典型菌落确认按8.4.1㊁8.4.3进行㊂13结果与报告根据证实为金黄色葡萄球菌阳性的试管管数,查M P N检索表(见附录C),报告每g(m L)样品中金黄色葡萄球菌的最可能数,以M P N/g(m L)表示㊂附录A培养基和试剂A.17.5%氯化钠肉汤A.1.1成分蛋白胨10.0g牛肉膏5.0g氯化钠75g蒸馏水1000m LA.1.2制法将上述成分加热溶解,调节p H至7.4ʃ0.2,分装,每瓶225m L,121ħ高压灭菌15m i n㊂A.2血琼脂平板A.2.1成分豆粉琼脂(p H7.5ʃ0.2)100m L脱纤维羊血(或兔血)5m L~10m LA.2.2制法加热溶化琼脂,冷却至50ħ,以无菌操作加入脱纤维羊血,摇匀,倾注平板㊂A.3B a i r d-P a r k e r琼脂平板A.3.1成分胰蛋白胨10.0g牛肉膏5.0g酵母膏1.0g丙酮酸钠10.0g甘氨酸12.0g氯化锂(L i C l㊃6H2O)5.0g琼脂20.0g蒸馏水950m LA.3.2增菌剂的配法30%卵黄盐水50m L与通过0.22μm孔径滤膜进行过滤除菌的1%亚碲酸钾溶液10m L混合,保存于冰箱内㊂A.3.3制法将各成分加到蒸馏水中,加热煮沸至完全溶解,调节p H至7.0ʃ0.2㊂分装每瓶95m L,121ħ高压灭菌15m i n㊂临用时加热溶化琼脂,冷至50ħ,每95m L加入预热至50ħ的卵黄亚碲酸钾增菌剂5m L摇匀后倾注平板㊂培养基应是致密不透明的㊂使用前在冰箱储存不得超过48h㊂A.4脑心浸出液肉汤(B H I)A.4.1成分胰蛋白质胨10.0g氯化钠5.0g磷酸氢二钠(12H2O)2.5g葡萄糖2.0g牛心浸出液500m LA.4.2制法加热溶解,调节p H至7.4ʃ0.2,分装16mmˑ160mm试管,每管5m L置121ħ,15m i n灭菌㊂A.5兔血浆取柠檬酸钠3.8g,加蒸馏水100m L,溶解后过滤,装瓶,121ħ高压灭菌15m i n㊂兔血浆制备:取3.8%柠檬酸钠溶液一份,加兔全血4份,混好静置(或以3000r/m i n离心30m i n),使血液细胞下降,即可得血浆㊂A.6磷酸盐缓冲液A.6.1成分磷酸二氢钾(K H2P O4)34.0g蒸馏水500m LA.6.2制法贮存液:称取34.0g的磷酸二氢钾溶于500m L蒸馏水中,用大约175m L的1m o l/L氢氧化钠溶液调节p H至7.2,用蒸馏水稀释至1000m L后贮存于冰箱㊂稀释液:取贮存液1.25m L,用蒸馏水稀释至1000m L,分装于适宜容器中,121ħ高压灭菌15m i n㊂A.7营养琼脂小斜面A.7.1成分蛋白胨10.0g牛肉膏3.0g氯化钠5.0g琼脂15.0g~20.0g蒸馏水1000m LA.7.2制法将除琼脂以外的各成分溶解于蒸馏水内,加入15%氢氧化钠溶液约2m L调节p H至7.3ʃ0.2㊂加入琼脂,加热煮沸,使琼脂溶化,分装13mmˑ130mm试管,121ħ高压灭菌15m i n㊂A.8革兰氏染色液A.8.1结晶紫染色液A.8.1.1成分结晶紫1.0g95%乙醇20.0m L1%草酸铵水溶液80.0m LA.8.1.2制法将结晶紫完全溶解于乙醇中,然后与草酸铵溶液混合㊂A.8.2革兰氏碘液A.8.2.1成分碘1.0g碘化钾2.0g蒸馏水300m LA.8.2.2制法将碘与碘化钾先行混合,加入蒸馏水少许充分振摇,待完全溶解后,再加蒸馏水至300m L㊂A.8.3沙黄复染液A.8.3.1成分沙黄0.25g95%乙醇10.0m L蒸馏水90.0m LA.8.3.2制法将沙黄溶解于乙醇中,然后用蒸馏水稀释㊂A.8.4染色法a)涂片在火焰上固定,滴加结晶紫染液,染1m i n,水洗㊂b)滴加革兰氏碘液,作用1m i n,水洗㊂c)滴加95%乙醇脱色约15s~30s,直至染色液被洗掉,不要过分脱色,水洗㊂d)滴加复染液,复染1m i n,水洗㊁待干㊁镜检㊂A.9无菌生理盐水A.9.1成分氯化钠8.5g蒸馏水1000m LA.9.2制法称取8.5g氯化钠溶于1000m L蒸馏水中,121ħ高压灭菌15m i n㊂附录B葡萄球菌肠毒素检验B.1试剂和材料除另有规定外,所用试剂均为分析纯,试验用水应符合G B/T6682对一级水的规定㊂B.1.1 A㊁B㊁C㊁D㊁E型金黄色葡萄球菌肠毒素分型E L I S A检测试剂盒㊂B.1.2p H试纸,范围在3.5~8.0,精度0.1㊂B.1.30.25m o l/L㊁p H8.0的T r i s缓冲液:将121.1g的T r i s溶解到800m L的去离子水中,待温度冷至室温后,加42m L浓H C L,调p H至8.0㊂B.1.4p H7.4的磷酸盐缓冲液:称取N a H2P O4㊃H2O0.55g(或N a H2P O4㊃2H2O0.62g)㊁N a2H P O4㊃2H2O2.85g(或N a2H P O4㊃12H2O5.73g)㊁N a C l8.7g溶于1000m L蒸馏水中,充分混匀即可㊂B.1.5庚烷㊂B.1.610%次氯酸钠溶液㊂B.1.7肠毒素产毒培养基B.1.7.1成分蛋白胨20.0g胰消化酪蛋白200m g(氨基酸)氯化钠5.0g磷酸氢二钾1.0g磷酸二氢钾1.0g氯化钙0.1g硫酸镁0.2g菸酸0.01g蒸馏水1000m Lp H7.3ʃ0.2B.1.7.2制法将所有成分混于水中,溶解后调节p H,121ħ高压灭菌30m i n㊂B.1.8营养琼脂B.1.8.1成分蛋白胨10.0g牛肉膏3.0g氯化钠5.0g琼脂15.0g~20.0g蒸馏水1000m LB.1.8.2制法将除琼脂以外的各成分溶解于蒸馏水内,加入15%氢氧化钠溶液约2m L校正p H至7.3ʃ0.2㊂加入琼脂,加热煮沸,使琼脂溶化㊂分装烧瓶,121ħ高压灭菌15m i n㊂B.2仪器和设备B.2.1电子天平:感量0.01g㊂B.2.2均质器㊂B.2.3离心机:转速3000g~5000g㊂B.2.4离心管:50m L㊂B.2.5滤器:滤膜孔径0.2μm㊂B.2.6微量加样器:20μL~200μL㊁200μL~1000μL㊂B.2.7微量多通道加样器:50μL~300μL㊂B.2.8自动洗板机(可选择使用)㊂B.2.9酶标仪:波长450n m㊂B.3原理本方法可用A㊁B㊁C㊁D㊁E型金黄色葡萄球菌肠毒素分型酶联免疫吸附试剂盒完成㊂本方法测定的基础是酶联免疫吸附反应(E L I S A)㊂96孔酶标板的每一个微孔条的A~E孔分别包被了A㊁B㊁C㊁D㊁E 型葡萄球菌肠毒素抗体,H孔为阳性质控,已包被混合型葡萄球菌肠毒素抗体,F和G孔为阴性质控,包被了非免疫动物的抗体㊂样品中如果有葡萄球菌肠毒素,游离的葡萄球菌肠毒素则与各微孔中包被的特定抗体结合,形成抗原抗体复合物,其余未结合的成分在洗板过程中被洗掉;抗原抗体复合物再与过氧化物酶标记物(二抗)结合,未结合上的酶标记物在洗板过程中被洗掉;加入酶底物和显色剂并孵育,酶标记物上的酶催化底物分解,使无色的显色剂变为蓝色;加入反应终止液可使颜色由蓝变黄,并终止了酶反应;以450n m波长的酶标仪测量微孔溶液的吸光度值,样品中的葡萄球菌肠毒素与吸光度值成正比㊂B.4检测步骤B.4.1从分离菌株培养物中检测葡萄球菌肠毒素方法待测菌株接种营养琼脂斜面(试管18mmˑ180mm)36ħ培养24h,用5m L生理盐水洗下菌落,倾入60m L产毒培养基中,36ħ振荡培养48h,振速为100次/m i n,吸出菌液离心,8000r/m i n 20m i n,加热100ħ,10m i n,取上清液,取100μL稀释后的样液进行试验㊂B.4.2从食品中提取和检测葡萄球菌毒素方法B.4.2.1牛奶和奶粉将25g奶粉溶解到125m L㊁0.25M㊁p H8.0的T r i s缓冲液中,混匀后同液体牛奶一样按以下步骤制备㊂将牛奶于15ħ,3500g离心10m i n㊂将表面形成的一层脂肪层移走,变成脱脂牛奶㊂用蒸馏水对其进行稀释(1ʒ20)㊂取100μL稀释后的样液进行试验㊂B.4.2.2脂肪含量不超过40%的食品称取10g样品绞碎,加入p H7.4的P B S液15m L进行均质㊂振摇15m i n㊂于15ħ,3500g离心10m i n㊂必要时,移去上面脂肪层㊂取上清液进行过滤除菌㊂取100μL的滤出液进行试验㊂B.4.2.3脂肪含量超过40%的食品称取10g样品绞碎,加入p H7.4的P B S液15m L进行均质㊂振摇15m i n㊂于15ħ,3500g离心10m i n㊂吸取5m L上层悬浮液,转移到另外一个离心管中,再加入5m L的庚烷,充分混匀5m i n㊂于15ħ,3500g离心5m i n㊂将上部有机相(庚烷层)全部弃去,注意该过程中不要残留庚烷㊂将下部水相层进行过滤除菌㊂取100μL的滤出液进行试验㊂B.4.2.4其他食品可酌情参考上述食品处理方法㊂B.4.3检测B.4.3.1所有操作均应在室温(20ħ~25ħ)下进行,A㊁B㊁C㊁D㊁E型金黄色葡萄球菌肠毒素分型E L I S A检测试剂盒中所有试剂的温度均应回升至室温方可使用㊂测定中吸取不同的试剂和样品溶液时应更换吸头,用过的吸头以及废液处理前要浸泡到10%次氯酸钠溶液中过夜㊂B.4.3.2将所需数量的微孔条插入框架中(一个样品需要一个微孔条)㊂将样品液加入微孔条的A~G 孔,每孔100μL㊂H孔加100μL的阳性对照,用手轻拍微孔板充分混匀,用黏胶纸封住微孔以防溶液挥发,置室温下孵育1h㊂B.4.3.3将孔中液体倾倒至含10%次氯酸钠溶液的容器中,并在吸水纸上拍打几次以确保孔内不残留液体㊂每孔用多通道加样器注入250μL的洗液,再倾倒掉并在吸水纸上拍干㊂重复以上洗板操作4次㊂本步骤也可由自动洗板机完成㊂B.4.3.4每孔加入100μL的酶标抗体,用手轻拍微孔板充分混匀,置室温下孵育1h㊂B.4.3.5重复B.4.3.3的洗板程序㊂B.4.3.6加50μL的TM B底物和50μL的发色剂至每个微孔中,轻拍混匀,室温黑暗避光处孵育30m i n㊂B.4.3.7加入100μL的2m o l/L硫酸终止液,轻拍混匀,30m i n内用酶标仪在450n m波长条件下测量每个微孔溶液的O D值㊂B.4.4结果的计算和表述B.4.4.1质量控制测试结果阳性质控的O D值要大于0.5,阴性质控的O D值要小于0.3,如果不能同时满足以上要求,测试的结果不被认可㊂对阳性结果要排除内源性过氧化物酶的干扰㊂B.4.4.2临界值的计算每一个微孔条的F孔和G孔为阴性质控,两个阴性质控O D值的平均值加上0.15为临界值㊂示例:阴性质控1=0.08阴性质控2=0.10平均值=0.09临界值=0.09+0.15=0.24B.4.4.3结果表述O D值小于临界值的样品孔判为阴性,表述为样品中未检出某型金黄色葡萄球菌肠毒素;O D值大于或等于临界值的样品孔判为阳性,表述为样品中检出某型金黄色葡萄球菌肠毒素㊂B.5生物安全因样品中不排除有其他潜在的传染性物质存在,所以要严格按照G B19489‘实验室生物安全通用要求“对废弃物进行处理㊂附录C金黄色葡萄球菌最可能数(M P N)检索表每g(m L)检样中金黄色葡萄球菌最可能数(M P N)的检索见表C.1㊂表C.1金黄色葡萄球菌最可能数(M P N)检索表阳性管数0.100.010.001M P N 95%置信区间下限上限000<3.0 9.5 0013.00.159.6 0103.00.1511 0116.11.218 0206.21.218 0309.43.638 1003.60.1718 1017.21.318 102113.638 1107.41.320 111113.638 120113.642 121154.542 130164.542 2009.21.438 201143.642 202204.542 210153.742 211204.542 212278.794阳性管数0.100.010.001M P N95%置信区间下限上限220214.542 221288.794 222358.794 230298.794 231368.794 300234.694 301388.7110 3026417180 310439180 3117517200 31212037420 31316040420 3209318420 32115037420 32221040430 323290901000 330240421000 331460902000 33211001804100 333>1100420注1:本表采用3个稀释度[0.1g(m L)㊁0.01g(m L)和0.001g(m L)]㊁每个稀释度接种3管㊂注2:表内所列检样量如改用1g(m L)㊁0.1g(m L)和0.01g(m L)时,表内数字应相应降低10倍;如改用0.01g (m L)㊁0.001g(m L)㊁0.0001g(m L)时,则表内数字应相应增高10倍,其余类推㊂。
![GBT_4789[1].40-2010_食品卫生微生物学检验_阪崎肠杆菌检验标准培训资料](https://uimg.taocdn.com/323c55ecf8c75fbfc77db227.webp)

GB4789-2016系列新标准的改变及应用作者:李卉来源:《现代食品》 2017年第8期摘要:本文将GB 4789-2016 系列新标准的改变与实际工作结合起来,对如何应用新标准做好基层微生物检验工作提出自己的想法。
关键词:GB 4789-2016;新标准;微生物检验中图分类号:D922.16标准的使用过程中会不断积累问题,随着实验技术的进一步提高,许多不适用的标准需要更新。
《中华人民共和国食品安全法》和《食品安全国家标准管理办法》规定,经食品安全国家标准审评委员会审查通过,国家卫生和计划生育委员会2016 年第11 号、2016 年第15 号、2016 年第17 号公告发布了多项食品安全国家标准。
其中GB 4789-2016《食品安全国家标准食品微生物学检验》系列标准共计18 项,包括GB 4789.1-2016 总则[1]、GB 4789.2-2016 菌落总数测定[2]、GB 4789.3-2016 大肠菌群计数[3] 等。
结合工作实际,现就总则及菌落总数、大肠菌群、霉菌和酵母、沙门氏菌、金黄色葡萄球菌、单核细胞增生李斯特氏菌、乳酸菌、阪崎肠杆菌几个项目新标准的改变做简单综述,并对下一步如何应用新标准做好基层微生物检验工作提出要求。
1 GB 4789-2016 系列新标准的改变2016 版新标准与2010 版标准相比,方法原理、实验仪器及设备、试剂耗材、检验程序与操作步骤、结果判读和报告要求均有所修改,还增加了部分新方法。
总则增加了附录A,微生物实验室常规检验用品和设备,修改了实验室基本要求,修改了样品的采集,修改了检验,修改了检验后样品的处理,删除了规范性引用文件[1];菌落总数,无实质性修改[2];大肠菌群增加了检验原理,修改了适用范围,修改了典型菌落的形态描述,修改了第二法平板菌落数的选择,修改了第二法证实试验,修改了第二法平板计数的报告[3];霉菌和酵母计数修改了设备和材料、修改了培养基和试剂、修改了检验程序和操作步骤、修改了结果与报告、修改了附录A、附录B 修改为第二法[4];沙门氏菌修改了检验流程和血清学检测操作程序,修改了附录A和附录B[5];金黄色葡萄球菌试验用增菌液统一修改为7.5% 氯化钠肉汤[6];单核细胞增生李斯特氏菌增加了“第二法单核细胞增生李斯特氏菌平板计数法”,增加了“第三法单核细胞增生李斯特氏菌MPN 计数法”,修改了范围[7];乳酸菌增加了乳酸菌总数计数培养条件的选择及结果说明,修改了改良MRS 培养基成分,修改了平板计数的接种方法和接种量[8];阪崎肠杆菌标准名称修改为“食品安全国家标准食品微生物学检验克罗诺杆菌属(阪崎肠杆菌)检验”, 修改了可疑菌落挑取数量[9]。
1中国卫生标准管理CHSM 16标准宣贯与执行马群飞中华人民共和国国家卫生和计划生育委员会2013年11月29日发布、2014年6月1日正式实施的GB 4789.28-2013《食品安全国家标准 食品微生物学检验 培养基和试剂的质量要求》(以下简称2013版标准)至今已经实施了5年[1]。
这个标准方法可以说是目前所有食品检验机构和食品生产企业微生物学实验室质量控制的基础。
虽然篇幅大、规定多,但是标准各章节的描述都不够详尽,在具体操作细节方面更是存在各种疏漏,检验机构困惑较多,理解应用时也常常出现偏差,影响了标准的实施效果。
检验机构接受现场评审时,在培养基和试剂质量控制环节被开不符合项的情作者单位:福建省疾病预防控制中心卫生微生物检验科,福建 福州 350001GB 4789.28-2013《食品安全国家标准 食品微生物学检验培养基和试剂的质量要求》应用现状【摘要】针对2014年6月1日起正式实施的GB 4789.28-2013《食品安全国家标准 食品微生物学检验 培养基和试剂的质量要求》,结合现行的实验室质量管理规范,分别从微生物学检验培养基质量控制的意义、培养基和试剂质量控制的要求、GB 4789.28-2013的具体要求和存在问题等方面分析了标准的应用现状。
通过探讨标准中各章节不够详尽的描述、具体操作细节存在的各种疏漏,包括与其他相关标准规定的不配套之处等问题,期望有助于检验人员更好地理解和应用标准,增加标准应用的可操作性。
【关键词】培养基;试剂;食品安全;国家标准;微生物;检验【中图分类号】R197 【文献标识码】A 【文章编号】1674-9316(2019)16-0001-03doi:10.3969/j.issn.1674-9316.2019.16.001Application Status of GB 4789.28-2013 “National Food Safety Standards -Food Microbiological Examination: Quality Requirements for Culture Mediums and Reagents”MA Qunfei Health Microbiology Laboratory, Fujian Center for Disease Control and Prevention, Fuzhou Fujian 350001, China[Abstract] In accordance with GB 4789.28-2013“National Food Safety Standards-Food Microbiological Examination: Quality Requirements for Culture Mediums and Reagents”, which was formally implemented on June 1, 2014, and combined with the existing laboratory quality management standards, the significance of quality control of culture medium and reagent for microbiological examination, the requirements for quality control of culture medium and reagent, and the specific requirements and existing problems of GB 4789.28-2013 were discussed respectively. The application status of the standard is analyzed in the aspects of questions and so on. By discussing the inadequate description of each chapter in the standard and various omissions in the specific operation details, including the incompatibility with other relevant standards, it is expected to help inspectors better understand and apply the standard and increase the operability of the standard application.[Keywords] culture medium; reagent; food safety; national standard; microbiology; examination况极为常见。
GB 4789.3-2010 食品安全国家标准食品微生物学检验大肠菌群计数前言本标准代替GB/T 4789.3-2008《食品卫生微生物学检验大肠菌群计数》。
本标准与GB/T 4789.3-2008相比,主要修改如下:——修改了标准的中英文名称;——"第二法大肠菌群平板计数法"的平板菌落数的选择范围修改为"15 CFU~150 CFU";——删除了"第三法大肠菌群Petrifilm TM测试片法"。
本标准的附录A、附录B为规范性附录。
本标准所代替标准的历次版本发布情况为:——GB 4789.3-1984、GB 4789.3-1994、GB /T 4789.3-2003、GB /T 4789.3-2008。
食品安全国家标准食品微生物学检验大肠菌群计数1 范围本标准规定了食品中大肠菌群(Coliforms)计数的方法。
本标准适用于食品中大肠菌群的计数。
2 术语和定义2.1 大肠菌群 coliforms在一定培养条件下能发酵乳糖、产酸产气的需氧和兼性厌氧革兰氏阴性无芽胞杆菌。
2.2 最可能数 most probable number,MPN基于泊松分布的一种间接计数方法。
3 设备和材料除微生物实验室常规灭菌及培养设备外,其他设备和材料如下:3.1 恒温培养箱:36 ℃±1 ℃。
3.2 冰箱:2 ℃~5 ℃。
3.3 恒温水浴箱:46 ℃±1 ℃。
3.4 天平:感量 0.1 g。
3.5 均质器。
3.6 振荡器。
3.7 无菌吸管:1 mL(具 0.01 mL 刻度)、10 mL(具 0.1 mL 刻度)或微量移液器及吸头。
3.8 无菌锥形瓶:容量 500 mL。
3.9 无菌培养皿:直径 90 mm。
3.10 pH 计或 pH 比色管或精密 pH 试纸。
3.11 菌落计数器。
4 培养基和试剂4.1 月桂基硫酸盐胰蛋白胨(Lauryl Sulfate Tryptose,LST)肉汤:见附录 A 中 A.1。
食品微生物学检验GB 4789 系列知识点汇总GB 4789.1-2016 食品卫生学检验总则一、2016版总则变更内容1.删除了标准中的英文名称、起草单位变更为中华人民共和国国家卫生和计划生育委员会国家食品药品监督管理总局。
2.删除了规范性引用文件。
3.修改了实验室基本要求:应具有相应的微生物专业教育或培训经历(如生物学、植物学、医学、食品科学与工程、食品质量与安全等与微生物有关的相关专业),具备相应的资质(应有岗位上岗证、生物安全上岗证和压力容器上岗证),能够理解并正确实施检验。
实验室生物安全操作和消毒知识(相关标准及培训,如GB 19489-2008 实验室生物安全通用要求、消毒技术规范(2002))。
应在检验过程中保持个人整洁与卫生,防止人为污染样品。
应在检验过程中遵守相关安全措施的规定,确保自身安全。
有颜色视觉障碍的人员不能从事涉及辨色的实验(即无颜色视觉障碍)。
②环境与设施--突出温度、湿度和洁净度。
生物危害程度应与实验室生物防护水平相适应:引起人和动物非常严重疾病,国家未发现或已宣布消灭的微生物,如天花病毒。
引起任何动物比较严重疾病,在人和人、人和动物之间传播如霍乱弧菌。
病原微生物分类成严重危害如沙门氏菌、单增李斯特氏菌。
BSL-1):操作第四类病原微生物(属适用范围如大肠埃希氏菌、枯草芽重要设备是超净工作台,它可以)实验室生物安全级别BSL-2):操作第三类病原微生物(属II级生物安全柜。
)BSL-3):操作第二类病原微生物BSL-4):操作第一类病原微生物消毒:是杀死微生物的物理或化学手段,但不一定杀死其中的孢子。
灭菌:是杀死和去除所有微生物及其中孢子的过程。
紫外线消毒(臭氧)空间熏蒸(如空间被霉菌微生物实验湿热灭菌或常用高压灭菌180℃1h或170℃2h)紫外线消毒法:紫外灯管放射一定波长,破坏细菌或病毒的DNA和RNA,使他们丧失生存能力和繁殖能力,从而达到灭菌目的。
紫外线的特点是对芽孢和营养细胞都能起作用,但细菌芽孢和霉菌芽孢对其抵抗力大,且紫外线穿透力极低,所以只能用于表面灭菌,对固体物质灭菌不彻底。
序号标准号
Standard No.
No年份标准号1
GB 4789012010
GB 4789022010
GB 4789032010
GB 4789042010
1GB/T 4789052003
062003 2GB/T 4789072008
082008 24GB/T 4789092008 GB 4789102010 3GB/T 4789112003 4GB/T 4789122003 5GB/T 4789132003 6GB/T 4789142003 GB 4789152010 7GB/T 4789162003 8GB/T 4789172003 GB 4789182010 9GB/T 4789192003 10GB/T 4789202003 11GB/T 4789212003 12GB/T 4789222003 13GB/T 4789232003 14GB/T 4789242003 15GB/T 4789252003 16GB/T 4789262003 23GB/T 4789272008 17GB/T 4789282003 18GB/T 4789292003 GB 4789302010 19GB/T 4789312003 20GB/T 4789322002 GB/T 4789332003 28GB/T 4789342008 GB 4789352010 21GB/T 4789362008 GB/T 4789372008 26GB/T 4789382008 27GB/T 4789392008 GB 4789402010
中文标准名称Standard Title in Chinese 英文标准
名称
Standard
Title in
English
状态State
食品安全国家标准 食品微生物学检验 总则现行 食品安全国家标准 食品微生物学检验 菌落总数测定现行 食品安全国家标准 食品微生物学检验 大肠菌群计数现行 食品安全国家标准 食品微生物学检验 沙门氏菌检验 现行 食品卫生微生物学检验 志贺氏菌检验 现行 食品卫生微生物学检验 致泻大肠埃希氏菌检验
食品卫生微生物学检验 副溶血性弧菌检验现行 食品卫生微生物学检验 小肠结肠炎耶尔森氏菌检验
食品卫生微生物学检验 空肠弯曲菌检验现行 食品安全国家标准 食品微生物学检验 金黄色葡萄球菌检验现行食品卫生微生物学检验 溶血性链球菌检验现行食品卫生微生物学检验 肉毒梭菌及肉毒毒素检验Microbiologi现行食品卫生微生物学检验 产气夹膜梭菌检验Microbiologi现行食品卫生微生物学检验 蜡样芽胞杆菌检验Microbiologi现行食品安全国家标准 食品微生物学检验 霉菌和酵母计数Microbiologi现行食品卫生微生物学检验 常见产毒霉菌的鉴定Microbiologi现行食品卫生微生物学检验 肉与肉制品检验Microbiologi现行食品安全国家标准 食品微生物学检验 乳与乳制品检验Microbiologi现行食品卫生微生物学检验 蛋与蛋制品检验Microbiologi现行食品卫生微生物学检验 水产食品检验Microbiologi现行食品卫生微生物学检验 冷冻饮品、饮料检验Microbiologi现行食品卫生微生物学检验 调味品检验Microbiologi现行食品卫生微生物学检验 冷食菜、豆制品检验Microbiologi现行食品卫生微生物学检验 糖果、糕点、蜜饯检验Microbiologi现行食品卫生微生物学检验 酒类检验Microbiologi现行食品卫生微生物学检验 罐头食品商业无菌的检验Microbiologi现行食品卫生微生物学检验 鲜乳中抗生素残留检验Microbiologi现行食品卫生微生物学检验 染色法、培养基和试剂Microbiologi现行食品卫生微生物学检验 椰毒假单胞菌酵米面亚种检验Microbiologi现行食品安全国家标准 食品微生物学检验 单核细胞增生李斯特氏菌M icrobiologi现行食品卫生微生物学检验 沙门氏菌、志贺氏菌和致泻大肠埃希氏菌
Microbiologi现行食品卫生微生物学检验 大肠菌群的快速检测Microbiologi现行食品卫生微生物学检验 粮谷、果蔬类食品检验Microbiologi作废食品卫生微生物学检验 双歧杆菌检验Microbiologi现行食品安全国家标准 食品微生物学检验 乳酸菌检验Microbiologi现行食品卫生微生物学检验 大肠埃希氏菌O157:H7/NM检验现行食品卫生微生物学检验 金黄色葡萄球菌计数作废食品卫生微生物学检验 大肠杆菌计数Microbiologi现行食品卫生微生物学检验 粪大肠菌群计数Microbiologi现行食品安全国家标准 食品微生物学检验 阪崎肠杆菌检验Microbiologi现行
Microbiologi现行
备注Remark
2004-01-01实施,代替GB/T 4789.5-1994 2004-01-01实施,代替GB/T 4789.6-1994 2008-11-01实施,代替GB/T 4789.7-2003 2009-03-01实施,代替GB/T 4789.8-2003 2009-03-01实施,代替GB/T 4789.9-2003 2004-01-01实施,代替GB/T 4789.11-1994 2004-01-01实施,代替GB/T 4789.12-1994 2004-01-01实施,代替GB/T 4789.13-1994 2004-01-01实施,代替GB/T 4789.14-1994 2004-01-01实施,代替GB/T 4789.16-1994 2004-01-01实施,代替GB/T 4789.17-1994 2004-01-01实施,代替GB/T 4789.19-1994 2004-01-01实施,代替GB/T 4789.20-1994 2004-01-01实施,代替GB/T 4789.21-1994 2004-01-01实施,代替GB/T 4789.22-1994 2004-01-01实施,代替GB/T 4789.23-1994 2004-01-01实施,代替GB/T 4789.24-1994 2004-01-01实施,代替GB/T 4789.25-1994 2004-01-01实施,代替GB/T 4789.26-1994 2009-03-01实施,代替GB/T 4789.27-2003 2004-01-01实施,代替GB/T 4789.28-1994 2004-01-01实施,代替GB/T 4789.29-1994 2004-01-01实施,代替GB/T 4789.31-1994 2002-10-01实施
2009-03-01实施,代替GB/T 4789.34-2003 2008-11-01实施
2009-03-01实施
2009-03-01实施。